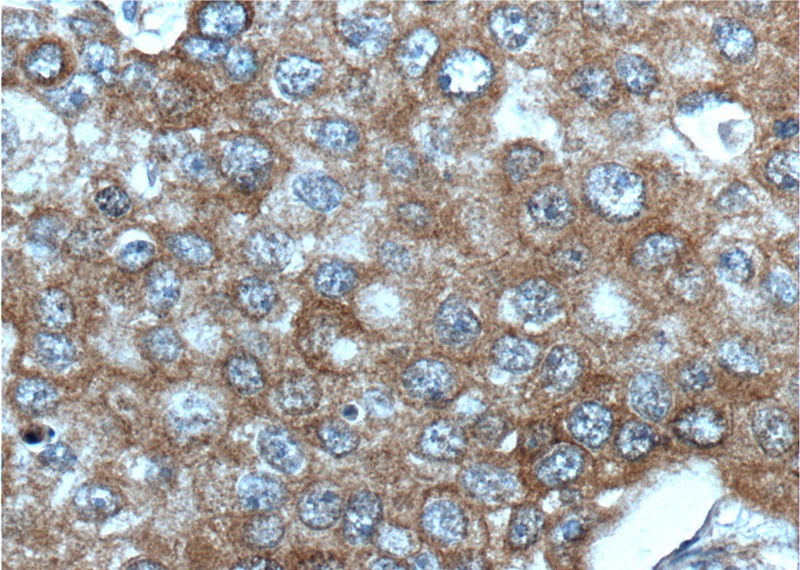
Immunohistochemistry of paraffin-embedded human breast cancer tissue slide using Catalog No:107280(IGF1R-Specific Antibody) at dilution of 1:200 (under 40x lens). heat mediated antigen retrieved with Tris-EDTA buffer(pH9).

-
Product Name
IGF1R-Specific antibody
- Documents
-
Description
IGF1R-Specific Mouse Monoclonal antibody. Positive WB detected in HepG2 cells, HeLa cells, HUVEC cells, MCF-7 cells. Positive IHC detected in human breast cancer tissue. Observed molecular weight by Western-blot: 130-140 kDa
-
Tested applications
ELISA, WB, IHC
-
Species reactivity
Human; other species not tested.
-
Alternative names
CD221 antibody; IGF I receptor antibody; IGF1R antibody; IGF1R-Specific antibody; IGFIR antibody; IGFR antibody; JTK13 antibody
-
Isotype
Mouse IgG1
-
Preparation
This antibody was obtained by immunization of Peptide (Accession Number: NM_000875). Purification method: Protein G purified.
-
Clonality
Monoclonal
-
Formulation
PBS with 0.02% sodium azide and 50% glycerol pH 7.3.
-
Storage instructions
Store at -20℃. DO NOT ALIQUOT
-
Applications
Recommended Dilution:
WB: 1:1000-1:10000
IHC: 1:50-1:500
-
Validations

HepG2 cells were subjected to SDS PAGE followed by western blot with Catalog No:107280(IGF1R-Specific Antibody) at dilution of 1:2000

Immunohistochemistry of paraffin-embedded human breast cancer tissue slide using Catalog No:107280(IGF1R-Specific Antibody) at dilution of 1:200 (under 10x lens). heat mediated antigen retrieved with Tris-EDTA buffer(pH9).
Immunohistochemistry of paraffin-embedded human breast cancer tissue slide using Catalog No:107280(IGF1R-Specific Antibody) at dilution of 1:200 (under 40x lens). heat mediated antigen retrieved with Tris-EDTA buffer(pH9).
-
Background
IGF1R, also named as CD221, belongs to the protein kinase superfamily, Tyr protein kinase family and Insulin receptor subfamily. IGF1R binds insulin-like growth factor 1 (IGF1) with a high affinity and IGF2 with a lower affinity. It has a tyrosine-protein kinase activity, which is necessary for the activation of the IGF1-stimulated downstream signaling cascade. When present in a hybrid receptor with INSR, IGF1R binds IGF1. The hybrid receptors composed of IGF1R and INSR isoform Long are activated with a high affinity by IGF1, with low affinity by IGF2 and not significantly activated by insulin, and that hybrid receptors composed of IGF1R and INSR isoform Short are activated by IGF1, IGF2 and insulin. In contrast, the hybrid receptors composed of IGF1R and INSR isoform Long and hybrid receptors composed of IGF1R and INSR isoform Short have similar binding characteristics, both bind IGF1 and have a low affinity for insulin. Defects in IGF1R may be a cause in some cases of resistance to insulin-like growth factor 1 (IGF1 resistance).
Related Products / Services
Please note: All products are "FOR RESEARCH USE ONLY AND ARE NOT INTENDED FOR DIAGNOSTIC OR THERAPEUTIC USE"
